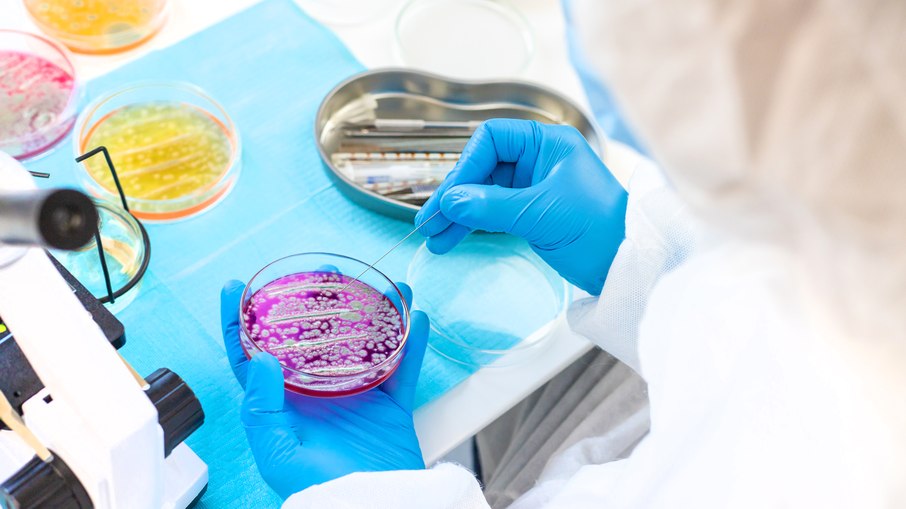

Um levantamento dos Centros de Controle e Prevenção de Doenças (CDC), publicado no Annals of Internal Medicine, mostrou um aumento de mais de 460% nas infecções causadas por uma bactéria quase intratável entre 2019 e 2023 nos Estados Unidos. O micróbio em questão é conhecido como NDM-CRE, parte de um grupo de bactérias resistentes a antibióticos chamado CRE.
Essas infecções atingem o pulmão (pneumonia), a corrente sanguínea, o trato urinário e feridas. São doenças graves, de difícil diagnóstico e que podem levar à morte. Segundo Danielle Rankin, epidemiologista do CDC, “selecionar o tratamento certo nunca foi tão complicado, por isso é vital que médicos tenham acesso a testes que ajudem na escolha da terapia adequada”.

O que é a bactéria NDM-CRE
O nome NDM vem de Nova Délhi metalo-β-lactamase, uma enzima que torna a bactéria resistente a quase todos os antibióticos existentes. Isso significa que, muitas vezes, os médicos não têm opções eficazes de tratamento.
O CDC lembra que, em 2020, já haviam sido registradas 12.700 infecções e 1.100 mortes por CRE nos EUA. O crescimento das variantes produtoras de NDM aumenta o risco de que esses números fiquem ainda mais altos.
Por que o aumento preocupa?
Além da alta mortalidade, a bactéria pode se espalhar rapidamente em hospitais e clínicas, especialmente quando falham medidas de higiene e prevenção, como lavar as mãos corretamente, usar luvas e aventais e desinfetar equipamentos. Outro problema é que muitos laboratórios não têm os recursos necessários para detectar a NDM-CRE rapidamente, o que atrasa o diagnóstico e facilita a transmissão.
“Um único caso já preocupa especialistas em doenças infecciosas. Essa tendência é alarmante, e vidas serão perdidas”, afirmou Susan S. Huang, professora da área.
Como enfrentar a ameaça
O CDC recomenda que profissionais de saúde se mantenham informados sobre a presença da bactéria, façam testes sempre que houver suspeita de CRE e sigam protocolos de prevenção. O órgão também reforça a necessidade de escolher antibióticos com cuidado e de fortalecer a vigilância em hospitais e clínicas para evitar surtos.
“O aumento acentuado da NDM-CRE mostra que enfrentamos uma ameaça crescente e que precisamos agir para proteger os pacientes”, concluiu Rankin.